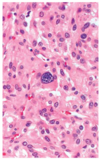

α-cells in the islets of Langerhans secrete ____
α-cells in the islets of Langerhans secrete glucagon

β-cells in the islets of Langerhans secrete ____ and ____
β-cells in the islets of Langerhans secrete insulin and c-peptide

δ-cells in the islets of Langerhans secrete _____
δ-cells in the islets of Langerhans secrete somatostatin

describe the effect of insulin on potassium
- promotes K+ movement INTO cells
- increases the action of the Na/K/ATPase
- this effect is used in treating life-threatening hyperkalemia by co-administering insulin + glucose

insulin promotes K+ movement (into or out of?) cells by ____
insulin promotes K+ movement into cells by increasing the action of the Na/K ATPase

list the infections associated with secondary DM
CMV
mumps
Coxsackie B virus

which 2 genetic syndromes are associated with secondary DM?
Down syndrome and Turner syndrome

T1DM has an association with HLA-___, ____ & ____
T1DM has an association with HLA-DR3, DR4/DQA1 & DQB1

T1DM is associated with which 4 viruses?
Coxsackie B
Rubella
CMV
mumps

T1DM is characterized by ____ reacting against endogenous ____ due to failure of ____
T1DM is characterized by immune effector cells reacting against endogenous B-cells antigens due to failure of self-tolerance in T-cells

____ antibodies may play a role in T1DM
islet cell antibodies may play a role in T1DM

the risk of T2DM increases with an increase in ____
the risk of T2DM increases with an increase in BMI

distribution of fat also plays a role in development of T2DM; patients with ___ obesity have higher risk of DM than those with ____ obesity
distribution of fat also plays a role in development of T2DM; patients with central obesity have higher risk of DM than those with peripheral obesity

list the 3 ways in which obesity can lead to T2DM
- production of free fatty acid
- antagonizing insulin action
- lipotoxicity
- change in adipokines levels
- decrease leptin and adiponectin levels in obesity
- inflammation
- role of IL-1
- amyloidosis within the islets

describe the presentation of a patient with the type 1 form of the condition seen in the image

- <40 yrs old & skinny (lack of insulin → catabolic state)
- fruity breath (caused by ketones)
- vomiting (ketones irritate area postrema)
- Kussmaul breathing (hyperventilating to compensate for met. acidosis)

describe the OGTT levels in normal, diabetic and pre-diabetic patients

_____ levels give an integrated measure of glucose concentrations over the previous 2-3 months because RBCs ____
glycosylated hemoglobin (HbA1c) levels give an integrated measure of glucose concentrations over the previous 2-3 months because RBCs live for 100 days

____ is the most common precipitating factor for DKA; what are 3 other causes?
missed insulin dose is the most common precipitating factor for DKA
- infection or acute illness
- trauma
- emotional disturbance

the hyperglycemia causes the characteristic ___ and ___ in DKA
the hyperglycemia causes the characteristic osmotic diuresis and dehydration in DKA

describe what is seen in the urine during DKA
positive for sugar and ketones

describe the electrolyte levels seen in DKA
increased K
decreased Na

describe the arterial blood gas levels seen in DKA
low pH (<7.3) with high anion gap metabolic acidosis

low bicarbonate
describe the management of DKA
saline infusion to replace fluid loss
insulin IV in small increments (to reduce glucose slowly)
potassium supplements

_____ occurs in elderly patients with T2DM (instead of DKA)
hyperosmolar hyperglycemia state occurs in elderly patients with T2DM (instead of DKA)